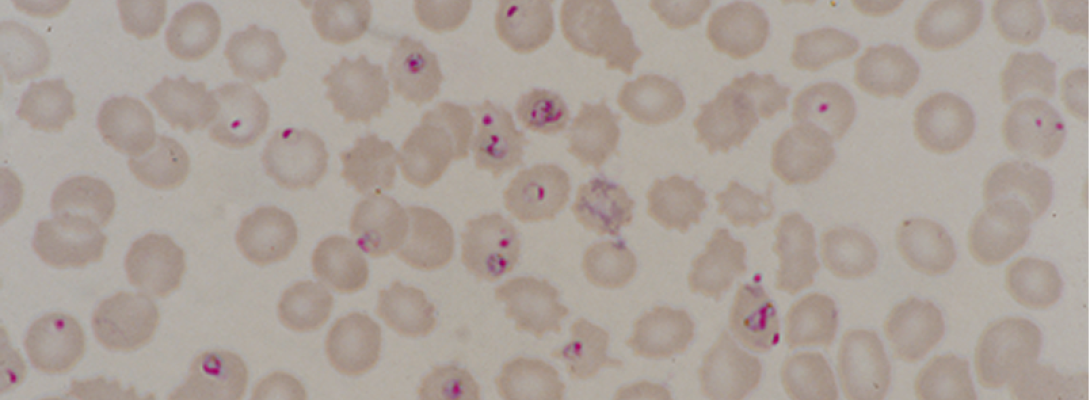
Plasmodium falciparum

VIEW-hub now tracks introduction and use of malaria vaccines. This topic page explores the introduction of these vaccines and their impact as part of a broader prevention strategy.
Table of Contents
- Overview
- Malaria Disease Burden
- Malaria Control Strategies
- Malaria Vaccines
- Vaccination as Part of a Broader Prevention Strategy
- Program Implementation Approaches
- Early Successes in Malaria Vaccination
- Key Takeaways
- Additional Resources and References
Overview
Malaria is a major threat to public health, responsible for 282 million cases and 610,000 deaths across 80 countries where it is endemic in 2024 [1]. Although its symptoms are sometimes mild, malaria can also be severe and even life-threatening, particularly for infants, young children, and pregnant women.
Malaria Disease Burden
There are five species of Plasmodium parasites that most commonly infect humans, of which P. falciparum (pictured in the image at the top) causes the highest morbidity and mortality. P. falciparum is the most prevalent species in Africa, which is home to 95% of malaria cases and deaths [1]. The majority (75%) of deaths in the region occur among children younger than 5 years, and more than half are concentrated in just three countries: Nigeria, the Democratic Republic of the Congo, and Niger. Within malaria-endemic countries, those who are already disadvantaged are also disproportionately affected as a result of poor housing and limited access to health care and preventive measures [2].
Malaria Control Strategies
In 2015, the World Health Assembly adopted a global strategy aiming to reduce malaria incidence and mortality by at least 90% by 2030 [2]. Effective treatment and prevention strategies—such as insecticide-treated nets (ITNs) and antimalarial drugs—led to some reductions in malaria deaths, but global trends are far from meeting these goals. Emerging challenges including increased insecticide and antimalarial drug resistance, reduced efficacy of rapid diagnostic tests, and invasive vector species. Newly licensed malaria vaccines can help overcome some of these challenges and save tens of thousands of lives.
Data on country-level introduction and use of these game-changing vaccines are now available on VIEW-hub.
Malaria Vaccines
Two malaria vaccines have been pre-qualified by WHO and recommended for use. To date, 25 countries, all in the African region, have introduced malaria vaccines nationally or subnationally, as seen in the VIEW-hub map below.
In October 2021, WHO recommended widespread use of the RTS,S/AS01 (RTS,S) malaria vaccine among children in sub-Saharan Africa and other regions with moderate to high P. falciparum transmission [3]. The RTS,S vaccine was the first malaria vaccine to be tested in phase 3 clinical trials and the first to be assessed in routine immunization programs in malaria-endemic areas [4]. The WHO recommendation came following a successful pilot program in Ghana, Kenya, and Malawi that reached more than 900,000 children and demonstrated that malaria vaccines could be administered through routine immunization programs despite their unique dosing schedule.
The RTS,S vaccine has been found to be safe and effective, with vaccine efficacy varying with differing vaccination strategies. Post-introduction studies from clinical trials and the pilot program provide evidence of a significant reduction in malaria burden following vaccination. A randomized controlled trial found that RTS,S provided substantial protection against clinical malaria: Across 11 study sites in seven countries, four doses of RTS,S provided 36% vaccine efficacy against clinical malaria in children aged 15–17 months [5]. Additional yearly doses have been shown to maintain vaccine efficacy for up to 50 months [6]. When the vaccine was administered just prior to the transmission season, areas with lower transmission often saw higher vaccine efficacy, while high transmission areas—where disease burden is higher—saw a greater reduction in malaria cases, indicating where the vaccine may have the most public health impact [7]. Results from the pilot program countries showed that 24 months after vaccination, there was a 9% reduction in all-cause mortality and 32% reduction in severe malaria hospitalizations among children under 5 years [8].
In October 2023, WHO recommended the R21/Matrix-M (R21) vaccine for the prevention of malaria among children [9]. Like the RTS,S vaccine, the R21 vaccine protects against P. falciparum malaria. Studies have found the R21 vaccine to be safe and effective, particularly when given just before the high transmission season. In a randomized phase 3 clinical trial, vaccine efficacy of three doses of R21 in children aged 5–36 months against multiple episodes of clinical malaria was 72% across seasonal sites and standard sites (where malaria transmission occurs throughout the year) [10]. In areas with highly seasonal malaria transmission, the vaccine was found to reduce symptomatic cases of malaria by 75% for 12 months following a three-dose series, compared to 67% at standard sites, with a fourth dose given a year later found to maintain high efficacy [10].
Both the RTS,S and R21 vaccines have been prequalified by WHO. WHO recommends countries choose a vaccine product based on programmatic characteristics, vaccine supply, and vaccine affordability considerations.
These two vaccines use the same mechanism to protect against malaria [11]. These pre-erythrocytic vaccines are based on the circumsporozoite protein and trigger the production of antibodies that target sporozoites (highly mobile forms of P. falciparum parasites that are injected by female anopheline mosquitoes) before they infect liver cells, preventing them from going on to invade red blood cells [4]. There are more than a dozen additional malaria vaccines in clinical development, many of which target different stages of the parasite. Blood stage vaccines target the parasite stage that infects red blood cells, while transmission-blocking vaccines aim to interrupt human-to-mosquito-to-human transmission by targeting the sexual stage of the parasite [12].
Of the 25 countries that have introduced malaria vaccines to date, 10 countries use the RTS,S vaccine, 14 countries use the R21 vaccine, and one country (Ghana) uses both vaccines.
Vaccination as Part of a Broader Prevention Strategy
Malaria vaccination efforts should complement rather than replace existing prevention and treatment efforts, as protection afforded by malaria vaccines declines over time. Further, combining vaccines with proven interventions like seasonal malaria chemoprevention (SMC) can provide the greatest impact in areas with seasonal transmission [13]. Combining SMC, ITNs, and malaria vaccines is estimated to reduce the risk of malaria by up to 90% [14]. These interventions can also be integrated to optimize service delivery. Although the introduction of malaria vaccines has not been seen to negatively impact the uptake of other malaria interventions, future communication and advocacy efforts will need to emphasize the importance of continuing other prevention strategies like the use of ITNs [14].
Program Implementation Approaches
Given the number of factors that impact malaria transmission (such as urbanization, land use, housing, rainfall, and temperature), some countries will benefit more from a targeted approach rather than adopting a universal malaria vaccination program, such as by introducing the vaccines subnationally to focus on areas with the highest disease burden. Potential vaccination strategies include an age-based approach, in which four doses are given to children throughout the year beginning at 5 months; a seasonal approach, in which three doses are given a month apart just before the high transmission season begins, with a fourth dose administered 12–18 months later; or a hybrid of the two [15]. There is also some flexibility on the timing of doses to account for seasonal transmission and to facilitate the integration of vaccination with other interventions. Although studies of both RTS,S and R21 vaccines demonstrate that a seasonal approach may improve efficacy in areas with seasonal transmission, it is logistically more complicated to implement this approach with campaigns compared to administering malaria vaccines through routine childhood immunization programs [7].
In countries that have introduced malaria vaccines, most (23, or 92%) use an age-based approach. Two countries (Mali and Guinea-Bissau) use a hybrid approach.
Early Successes in Malaria Vaccination
Though we are still in the early stages of malaria vaccine rollout, several major successes have already been achieved.
Millions of children have been protected.
Approximately seven million children in Ghana, Kenya, and Malawi were vaccinated between 2019 and 2024 through the Malaria Vaccine Implementation Programme [14,16]. Uptake in these countries was slow but has increased over time, with first- and third-dose coverage collectively reaching 84% and 78%, respectively, in 2023 [17]. One year after malaria vaccines were rolled out in Nigeria, more than 200,000 children have been vaccinated with the first dose [18].
Vaccine supply is ramping up.
Initial supply constraints have started to resolve, thanks to the WHO prequalification of a second vaccine and increased manufacturing capacity.
Financial barriers are being addressed through price cuts and donor support.
Recent price cuts make malaria vaccines more accessible, and the resulting cost savings will enable millions more children to be protected [19].
Gavi, the Vaccine Alliance has provided support to help deliver more than 39 million doses of malaria vaccines to children in 25 countries. They estimate that they will immunize another 50 million children against malaria between 2026–2030, averting approximately 170,000 deaths [20]. Despite this funding, additional support will be critical to scale up malaria vaccination programs in countries that will benefit most.
Key Takeaways
- The recent introduction of malaria vaccines will hopefully mitigate the disproportionate disease burden for children living in the African region.
- Vaccines are a promising tool that should be used as part of a comprehensive malaria control strategy alongside other prevention and treatment interventions.
- Program implementation should not take a one-size-fits-all-approach due to the focal and dynamic nature of malaria transmission and heterogenous disease burden.
- Donor funding has been invaluable in malaria vaccine rollout, but further support will be needed to scale up immunization efforts.
Additional Resources
Malaria vaccine: WHO position paper
References
- Malaria. World Health Organization. Accessed February 3, 2026. https://www.who.int/news-room/fact-sheets/detail/malaria
- Global technical strategy for malaria 2016–2030, 2021 update. World Health Organization. Accessed February 3, 2026. https://www.who.int/publications/i/item/9789240031357
- WHO recommends groundbreaking malaria vaccine for children at risk. World Health Organization. Accessed February 3, 2026. https://www.who.int/news/item/06-10-2021-who-recommends-groundbreaking-malaria-vaccine-for-children-at-risk
- Laurens MB. RTS,S/AS01 vaccine (Mosquirix™): an overview. Hum Vaccin Immunother. 2019;16(3):480–489. doi:10.1080/21645515.2019.1669415
- RTS,S Clinical Trials Partnership. Efficacy and safety of RTS,S/AS01 malaria vaccine with or without a booster dose in infants and children in Africa: final results of a phase 3, individually randomised, controlled trial. Lancet. 2015;386(9988):31-45. doi:10.1016/S0140-6736(15)60721-8
- Osei-Tutu L, Kariuki SK, Lee CK, R Fabre, Bii DK, Adjei S, et al. Sustained efficacy of the RTS,S/AS01E malaria vaccine over 50 months of follow-up when used in full-dose or fractional-dose regimens in young children in Ghana and Kenya: final results from an open-label, phase 2b, randomised controlled trial. Lancet Glob Health. 2025;13(10):e1723-e1736. doi:10.1016/S2214-109X(25)00272-4
- How effective are malaria vaccines? Gavi, the Vaccine Alliance VaccinesWork. Accessed February 3, 2026. https://www.gavi.org/vaccineswork/how-effective-are-malaria-vaccines
- Asante KP, Mathanga DP, Milligan P, Akech S, Oduro A, Mwapasa V, et al. Feasibility, safety, and impact of the RTS,S/AS01E malaria vaccine when implemented through national immunisation programmes: evaluation of cluster-randomised introduction of the vaccine in Ghana, Kenya, and Malawi. Lancet. 2024;403(10437):1660-1670. doi:10.1016/S0140-6736(24)00004-7
- WHO recommends R21/Matrix-M vaccine for malaria prevention in updated advice on immunization. World Health Organization. Accessed February 3, 2026. https://www.who.int/news/item/02-10-2023-who-recommends-r21-matrix-m-vaccine-for-malaria-prevention-in-updated-advice-on-immunization
- Datoo MS, Dicko A, Tinto H, Ouédraogo J, Hamaluba M, Olotu A, et al. Safety and efficacy of malaria vaccine candidate R21/Matrix-M in African children: a multicentre, double-blind, randomised, phase 3 trial. Lancet. 2024;403(10426):533-544. doi:10.1016/S0140-6736(23)02511-4
- Two vaccines, one target: How the RTS,S and R21 malaria vaccines work. Gavi, the Vaccine Alliance VaccinesWork. Accessed February 3, 2026. https://www.gavi.org/vaccineswork/two-vaccines-one-target-how-rtss-and-r21-malaria-vaccines-work
- Sallam M, Al-Khatib AO, Al-Mahzoum KS, Abdelaziz DH, Sallam M. Current Developments in Malaria Vaccination: A Concise Review on Implementation, Challenges, and Future Directions. Clin Pharmacol. 2025;17:29–47. doi:10.2147/CPAA.S513282
- Dicko A, Ouedraogo J, Zongo I, Sagara I, Cairns M, et al. Seasonal vaccination with RTS,S/AS01E vaccine with or without seasonal malaria chemoprevention in children up to the age of 5 years in Burkina Faso and Mali: a double-blind, randomised, controlled, phase 3 trial. Lancet Infect Dis. 2024;24(1):75-86. doi:10.1016/S1473-3099(23)00368-7.
- Rolling out vaccines to beat malaria together: Time to harness the power of immunisation for a malaria-free future. Gavi, the Vaccine Alliance. Accessed February 3, 2026. https://www.gavi.org/sites/default/files/white-paper/2025/Rolling-out-vaccines-to-beat-malaria-together-insight-paper.pdf
- Malaria vaccine: WHO position paper – May 2024. World Health Organization. Accessed February 3, 2026. https://www.who.int/teams/immunization-vaccines-and-biologicals/policies/position-papers/malaria
- Malaria vaccine implementation programme. World Health Organization. Accessed February 3, 2026. https://www.who.int/initiatives/malaria-vaccine-implementation-programme
- World malaria report 2024. World Health Organization. Accessed February 3, 2026. https://www.who.int/teams/global-malaria-programme/reports/world-malaria-report-2024
- Malaria vaccination reduces hospitalisations, deaths of children in northwestern Nigeria. Gavi, the Vaccine Alliance VaccinesWork. Accessed March 3, 2026. https://www.gavi.org/vaccineswork/kebbi-malaria-vaccination-rolls-back-hospitalisations-deaths-children
- Gavi and UNICEF announce equitable pricing deal for malaria vaccine to protect 7 million more children by end of decade. UNICEF. Accessed February 3, 2026. https://www.unicef.org/press-releases/gavi-and-unicef-announce-equitable-pricing-deal-malaria-vaccine-protect-7-million
- Protecting Our Future: Investment Opportunity 2026-2030. Gavi, the Vaccine Alliance. Accessed February 3, 2026. https://www.gavi.org/sites/default/files/investing/funding/resource-mobilisation/Gavi-Investment-Opportunity-2026-2030.pdf#page=20


